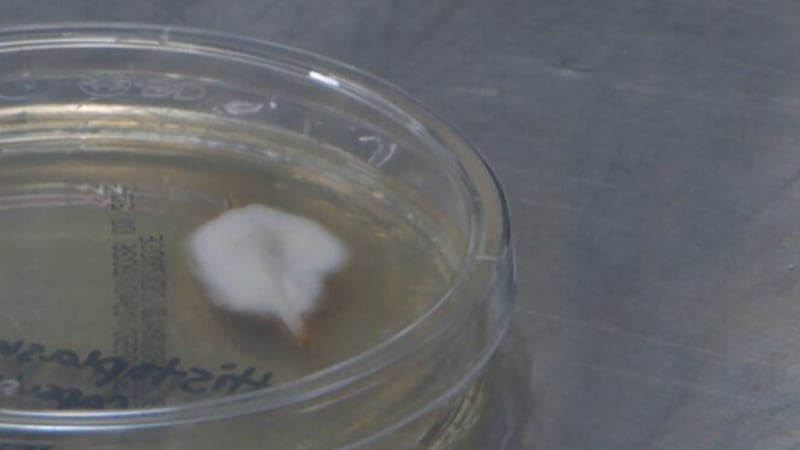
Nashville boy living with rare complication from histoplasmosis, fungal infection rising in...

Updated: 19 hours ago
|A brutal shot of arctic air will move into Middle Tennessee and Southern Kentucky for the second half of the weekend, making it dangerous to be outdoors for extended periods of time.
Updated: 20 hours ago
|Nashville boy living with rare complication from histoplasmosis, fungal infection rising in Middle Tennessee
Updated: 21 hours ago
|Metro Nashville has announced that new smart signals will be put into use at 36 intersections along Lebanon Pike.
Updated: 24 hours ago
|A school bus was involved in a crash on Bell Road on Friday morning.
Updated: Dec. 12, 2025 at 7:09 AM CST
|A 40-year-old man is facing charges following a roadside fight in South Nashville back in November.
Updated: Dec. 12, 2025 at 6:05 AM CST
|A man was found shot multiple times in a home on Park Lane Thursday night.